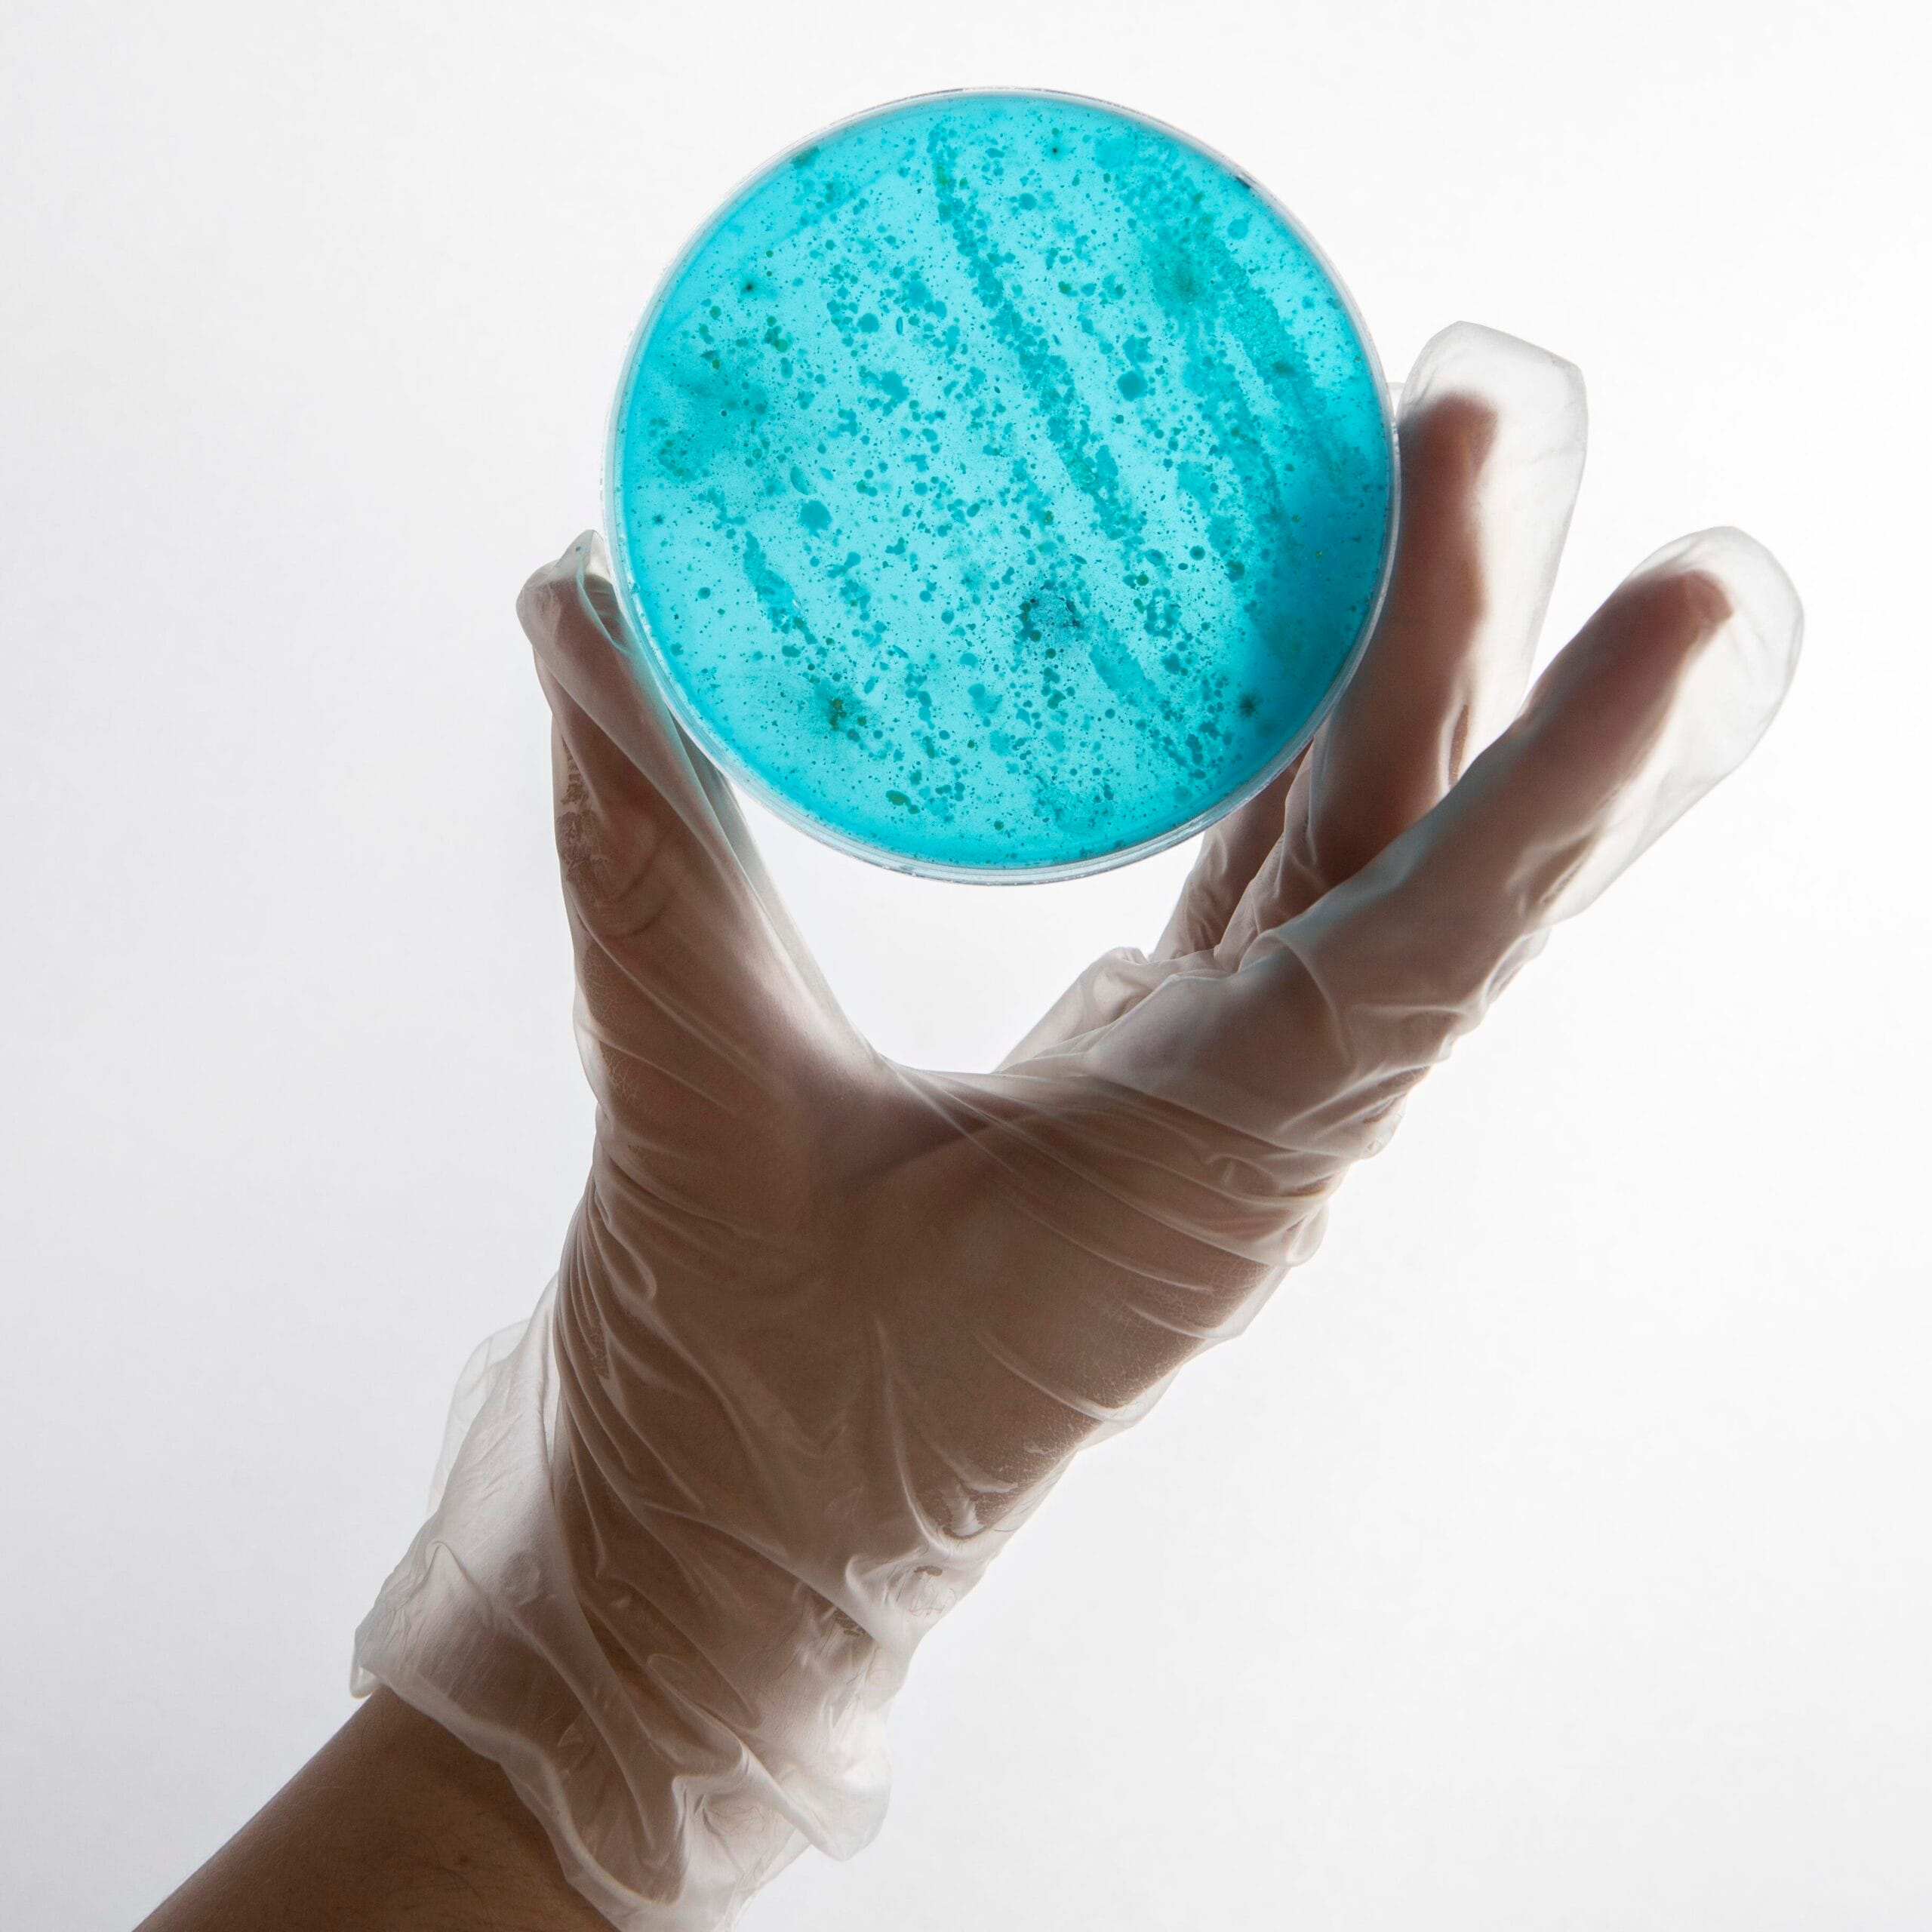

O Poder da Ciência da Nutrição em Seus Objetivos
A ciência da nutrição é a estratégia precisa para atingir seus objetivos de saúde. Ela vai além de calorias, focando nas reações bioquímicas que afetam disposição, cognição e hormônios. Usamos evidências científicas para atender suas necessidades únicas (macronutrientes, micronutrientes), garantindo planos que proporcionam resultados duradouros e sustentáveis.
Ao adotar a ciência nutricional, você escolhe a precisão. O objetivo pode ser performance, gerenciamento de doenças, composição corporal ou energia. Nosso papel é transformar estudos científicos complexos em um plano alimentar prático e alinhado ao seu dia a dia. Isso faz com que cada escolha alimentar seja um passo intencional em direção à sua meta.

Os resultados vêm do conhecimento, não de modismos. Aplicamos a ciência para otimizar seu metabolismo, melhorar a saúde intestinal e garantir que seu corpo prospere com os recursos certos. Se você deseja trocar o “achismo” por resultados reais e mensuráveis, a hora é de incorporar o rigor científico na sua alimentação. A ciência da nutrição é o motor do seu sucesso em saúde.

